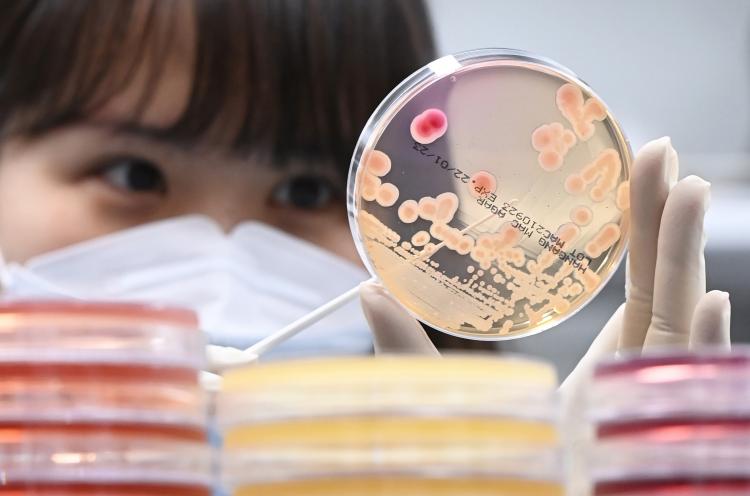

최신기사
- 李 대통령 “국민이 맡긴 수사기소권으로 증거조작, 납치살인보다 나쁜 짓”
- 여야, 대미투자특별법 12일 본회의 처리
- 이 대통령, 한·필리핀 ‘제조업·에너지·인프라 현대화’ 협력
- 고등학생 34% “스마트폰 공부 방해”… 75%는 옆에 둬
- 강선우·김경 신병 확보한 경찰… ‘13개 의혹’ 김병기 정조준
- 전남학생공공외교스쿨 3기 출범… 체계화된 과정 운영
- 남구 시민고충처리爲, 권익위원장 표창
- 광주시교육청, 교통안전 캠페인 실시
- 與, 인천시장 후보 박찬대 단수공천… 정청래 “정권교체 일등공신”
- 국힘, 지선 앞 ‘90년대생 청년’ 인재 5명 영입… “미래세대 중심 정책 혁신”
광주 초등학교 식중독 의심 사례 43건으로 늘어… 입원 3명
작성 : 2025년 07월 07일(월) 16:57 가+가-
광주 한 초등학교에서 발생한 식중독 의심 사례가 43건으로 늘었다.
7일 광주 북구에 따르면 지난 4일부터 집계된 북구 A 초등학교 내 식중독 의심 사례가 이날 오후 기준 43건(학생 39명·교사 4명)을 기록했다.
이중 3명이 복통과 구토 등 증상을 보여 입원 치료를 받고 있다.
이날 하루에만 학생 11명이 식중독 의심 증상을 신고한 것으로 확인됐다.
A 초교는 신고 전날 급식으로 수육과 보쌈김치를 제공했다.
식중독 의심 증상이 발생한 A 초교는 급식을 중단하고 대체식을 제공하고 있다.
황정식 기자 hgs9354@naver.com
7일 광주 북구에 따르면 지난 4일부터 집계된 북구 A 초등학교 내 식중독 의심 사례가 이날 오후 기준 43건(학생 39명·교사 4명)을 기록했다.
이중 3명이 복통과 구토 등 증상을 보여 입원 치료를 받고 있다.
이날 하루에만 학생 11명이 식중독 의심 증상을 신고한 것으로 확인됐다.
A 초교는 신고 전날 급식으로 수육과 보쌈김치를 제공했다.
식중독 의심 증상이 발생한 A 초교는 급식을 중단하고 대체식을 제공하고 있다.
황정식 기자 hgs9354@naver.com
많이 본 뉴스
종합
- 1배심원제 전격 도입… 전남광주특별시장 민주경선 ‘요동’
- 2국민의힘 “與, 대구·경북 시도민 우롱 말라”… TK 통합법 처리 촉구
- 3美국무부, 중동 대피령… “대이란 공격 크게 늘릴 것”
- 4전남교육청, 6·3 지방선거 앞두고 공직선거법 교육 실시
- 5李 대통령 “국민이 맡긴 수사기소권으로 증거조작, 납치살인보다 나쁜 짓”
- 6전남교육청, ‘성고충심의위원회’ 교육지원청‧본청 이관
- 7『장성교육지원청, 말레이시아 에코스쿨 방문, 대한민국 지방정부 최초 국제교류 성사』
- 8여야, 대미투자특별법 12일 본회의 처리
- 9이 대통령, 한·필리핀 ‘제조업·에너지·인프라 현대화’ 협력
- 10강성휘, ‘무안반도 통합 특례시’ 공식 제안
뉴스
- 1국민의힘 “與, 대구·경북 시도민 우롱 말라”… TK 통합법 처리 촉구
- 2전남교육청, 6·3 지방선거 앞두고 공직선거법 교육 실시
- 3『장성교육지원청, 말레이시아 에코스쿨 방문, 대한민국 지방정부 최초 국제교류 성사』
- 4여야, 대미투자특별법 12일 본회의 처리
- 5고등학생 34% “스마트폰 공부 방해”… 75%는 옆에 둬
- 6강선우·김경 신병 확보한 경찰… ‘13개 의혹’ 김병기 정조준
- 7전남학생공공외교스쿨 3기 출범… 체계화된 과정 운영
- 8조선대학교병원 제26대 병원장 외과 최남규 의학박사 취임
- 9與 서영교 “관봉권 상설특검, 남부지검 관련자 끝까지 수사해 밝혀야”
- 10광주시교육청, 교통안전 캠페인 실시
시군별뉴스
- 1李 대통령 “국민이 맡긴 수사기소권으로 증거조작, 납치살인보다 나쁜 짓”
- 2남구 시민고충처리爲, 권익위원장 표창
- 3‘강경파’ 하메네이 차남 집권시… 이란전 3대 시나리오
- 4“‘보복공격 피해 집중’ UAE, 이란 미사일기지에 반격 검토”
- 5구윤철 “대미투자, 공짜로 주는 돈 아냐…원리금 회수·기업 기회”
- 6목포대, 통합대학 첫 입학식 개최
- 7日법원, 옛 통일교에 해산 명령, 청산 절차 시작… 日정부 환영
- 8광산구, 자치구 유일 퇴직 공무원 사회공헌 신규사업 선정
- 9서구, ‘걸어서 100세까지’ 건강생활 지원
- 10광주은행, 제16기 대학생 홍보대사 모집
오피니언
Copyright © 2019 대한일보. All Rights Reserverd.
